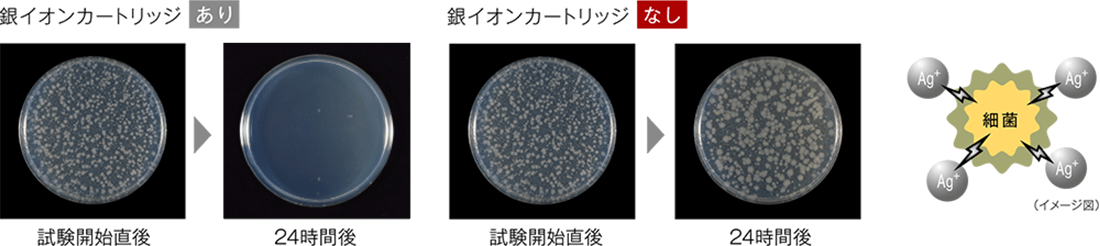
銀イオンカートリッジの除菌効果

【工事費込み】RSW-SD401LPEA[おかってカゴ][ハイグレード][自立脚付きタイプ]|リンナイ 食洗機 ドアパネル型|幅45cm・ディープタイプ・スライドオープン
販売価格: 154,968円(税込)
オプションにより価格が変わる場合もあります。
商品詳細
RSW-SD401LPEA
「おかってカゴ」を採用したハイグレードのディープタイプ。
使いやすい「おかってカゴ」を採用し、食器や調理器具を効率よく収納できるハイグレードモデル。優れた洗浄力と使いやすさを兼ね備え、毎日の後片付けを快適にサポートします。
RSW-SD401LPEAの機能
※ 交換時期は使用開始から2年です。(毎日2回標準コースで365日使用した場合)
より深く、さらに広くたくさん入るから、 食器と調理器具も一度に洗えます
大容量を活かして、大きな食器の収納や、食器と調理器具をまとめて洗うこともできます。例えば、ホームパーティーでたくさんの料理をつくっても、まとめて洗えるので後片付けはラクラクです。

*庫内容積測定基準については、下方は最下部にある食器カゴの線材の下部とする。(食器カゴから下方への部分的な突起は除く)水槽蓋の裏面は庫内の天面部とし、左右方向、前後 方向は庫内壁とする。(ノズルは除く)
※1 RSW-405LP・405GP・405AAシリーズとの比較[リンナイ(株)調べ]
少人数のご家庭でも深型タイプ。
理由は、1日分をまとめて洗えるから。例えば、ご夫婦とお子様1人の3人家族なら、食器の量は標準タイプの容量でも十分。でも、深型タイプなら朝と夜の食事で使った食器と調理器具もまとめて洗えます。食器洗 いの手間も負担も減らすことができます。

マルチショットでスミズミまで均等に洗浄する「タワーウォッシャー」
水圧で上下に伸びるセンターのタワーノズルが水平方向に、下部回転式ノズルが垂直方向に高圧シャワーをくまなく噴射し、重なった食器の間からカゴの端にセットされた食器、スプーンやフォークの小物の細部にいたるまで立体的に洗浄。汚れたフライパンやボウルなどもしっかり洗い流します。

こびりついた汚れもしっかり洗浄
タワーノズルと下部回転式ノズルから噴射する高圧シャワーが、庫内のあらゆるところに拡散し、大皿のふちからグラスの底までムラなく洗浄。カレーを食べた後の大皿や、トマトジュースの残りが付着したコップの底も、まんべんなくキレイに洗い流します。※1
※1 実際にRSW-D401LPA[標準コース]で洗った写真

【おかってカゴ】形状が違う食器をまとめて入れたい派
広めにピン幅を取った可動式レールによって、形や大きさの違う食器も簡単にセットできます。深めの和食器が多いご家庭に特におすすめのカゴです。カゴのラックを折りたたむことで、大きな調理器具も収まり、まとめて洗えます。

下カゴ
可動式レールによって3つのカゴがそれぞれ左右にスライド。入れたい食器のサイズにあわせてスペースを確保できるだけでなく、セットしやすさも格段にアップしています。


上カゴ
左右に分割して折りたためるフラップ式サークルラックを採用。上部にスペースを確保して下カゴに長皿や調理器具をセットし、コップやグラスとまとめて洗えます。

下カゴ:フレキシブルな可動式レール

形の違う食器も悩まずセット
可動式レールと広めのピンで自由度の高いセットが可能。食器の形や大きさを揃えなくても、まとめて入ります。

長さのある皿もスッと入る
上カゴのラックの左側をたたんで上部に大きな空間を確保。オーバルのカレー皿や魚用の長皿などをセットできます。

料理に使ったお鍋も一緒に
可動式レールを左側に寄せて、上カゴのラックの右側をたためば、下カゴに料理に使った鍋も一緒にセットできます。

上カゴ:分割して折りたためるラック

左右別々に折りたためる
片方ずつ折りたためるから、ラックの左側にコップやグラスをセットしたまま、右側をたたんで調理器具が入れられます。
いろいろ入って変幻自在な「フリーラック」
プラスチック容器を洗いたい、フライパンやボウルなどの調理器具も洗いたい、グラスや小鉢を追加して洗いたい、そんな時に活躍するのが「フリーラック」。入れるものにあわせてカゴの形状をさまざまなパターンに変えられるため、食器以外もまとめて洗いたい時に便利です。


軽い食器も、たくさんのグラスも、しっかりセット。
水圧でとばされやすいプラスチック容器をホールドした状態で、しっかり洗えます。またグラスや湯のみを6人分程度セットすることもできます。

料理に使った鍋やボウルも一緒に。
完全にフラットになるため、鍋やボウルなどの調理器具※1もセットして、一緒に洗えてひと手間減ります。
※1 深さ11センチ以下の調理器具が入ります。

フライパンも洗えるのがうれしい。
ラックをスライドさせ、セットしたフライパンを挟み込んで倒れないようホールド。ラックには、フライ返しや泡だて器などもセットできます。

大きな食器もラクにセットできます。
ラックをすべてたためば、下カゴから天面まで広いスペースを確保できます。大きなお皿※2だって、気にせずセット可能です。
※2 大皿の入る目安 おかってカゴ/直径27cm以下の場合:4点、直径30cm以下の場合:3点、ぎっしりカゴ/直径27cm以下の場合: 6点、直径30cm以下の場合:3点(30cmの大皿は1点ずつスペースを空けて入れてください。)
食器をセットしやすい「折りたたみサークルラック」[上カゴ]
用途にあわせて折りたたむことができる、洗浄性を高めたサークル状のラック。上カゴを外さずに、茶わんなどを下カゴの奥にラクにセットできます。

浮遊カビ菌※1やニオイを抑える「プラズマクラスター」技術
イオンの力で浮遊カビ菌※1や付着したニオイを抑制する注目の技術「プラズマクラスター」を食器洗い乾燥機に搭載しました。
※1〈浮遊カビ菌〉 ●試験機関(: 一財)石川県予防医学協会●試験方法:約31m³(約8畳相当)の試験空間にプラズマクラスターイオンを放出し、浮遊カビ菌をエアーサンプラーにて測定。(プラズマクラスターイオン濃度:25,000個/cm³)■試験結果:約83分で除去率99% ※2 水分子に取り囲まれていないイオンと比較。シャープ(株)調べ。

洗浄直後のクリーンな状態をキープ
食器の乾燥時に外気から取り込まれる空気をプラズマクラスターイオンが浄化。高濃度なプラズマクラスターイオンにより、浮遊カビ菌※1の分解・除去に加え、付着しているカビ菌の増殖も抑制します。また手洗いした食器も「クリーンキープコース」で保管すれば清潔さを保ちます。
※3〈付着カビ菌の増殖抑制〉●試験依頼先:(一財)日本食品分析センター●試験成績書:第12076306004-01号(2012年9月6日発行)●試験方法:シャープ(株)にて約20m³(約5畳相当)の試験空間にカビ菌を付着させた塩ビ板を置き、プラズマクラスターイオンを放出し、カビ菌を3日間増殖させたものを試験依頼。JISZ2911を参考にしてカビ発育面積を比較。(プラズマクラスターイオン濃度:25,000個/cm³)■試験結果:3日後に付着カビ菌の増殖を抑制。

銀イオンの除菌効果で清潔長続きの「銀イオンカートリッジ」
洗浄から高温水すすぎの行程で銀イオンが溶け出し、抗菌作用のある水が庫内に拡散し、食器や水槽全体に抗菌※1コートを生成。銀イオンが細菌に浸入し、酵素の働きを停止させて繁殖を抑制します。水槽内に残った水も銀イオンの力で除菌効果を発揮するため、庫内の清潔を保ちます。

銀イオンカートリッジの除菌効果※2
※1 試験機関:(一財) ボーケン品質評価機構 試験方法:JIS Z2801抗菌加工 製品-抗菌性試験方法・抗菌効果試験結果:運転終了後の水槽内壁面の抗菌活性値2.0以上 ※2 試験機関:(一財)日本食品分析センター第14127054001-01号 試験方法:水槽内残水中の菌の減少率測定 試験結果:99%以上の除菌効果 試験は1種類のみの菌で実施しています。すべての菌を除菌できるわけではありません。
庫内をキレイに保つ「庫内洗浄コース」
クエン酸や食酢などを入れて運転することで、水槽内部のカルキ成分を除去。定期的にお手入れすることで庫内をキレイに保つことができます。

写真はRSW-D401LPAです。
水滴や水槽のニオイを軽減「からっとキープ」
ヒーター加熱による乾燥運転の後に、乾燥ファンのみで運転。食器をスミズミまで余熱で乾燥させ、からっと感をキープ。水槽内や食器などに水滴が残ることや、水槽のニオイなどを抑えます。

自動で節水、省エネしてくれる「エコギア」
庫内温度センサーと排気温度センサーのダブルのセンサーで、庫内の食器量や排気温度をチェック。食器量にあわせてすすぎ回数を調整、乾燥時のヒーターを制御して庫内の温度を最適に保つので、水道代と電気代を抑えることができます。


※1 RSW-D401LPAの標準コース:食器点数47点(6人分) ※2 RSW-D401LPAの標準コース(エコギア作動時)
低ランニングコスト運転の「夜エココース」
寝ている間に洗浄・乾燥するコース。ヒーターの消費電力を抑えながら、ゆっくり洗浄、乾燥し、ランニングコストを抑えて運転します。朝起きたら、食器がキレイに、しかも節約にもなるうれしい機能です。

※4 1回あたりの経費例(食器点数47点、小物点数24点の場合)●RSW-D401LPA「標準コース」「夜エココース」で洗った場合(60℃お湯接続) ●手洗い:洗い桶に40℃のお湯10Lをためて洗った後、毎分6L・12.8分間すすぎ洗いした場合 ●算出基準料金(税込) ○水道料金:137円/m3(税込)○下水道使用料:125円/m3(税込)〔日本電機工業会調べ〕 ○電力料金目安単価31円/kWh(税込)【2022年7月改定】〔家電公取協調べ〕 ○ガス料金(都市ガス):222円/m3(税込) <リンナイ(株)調べ> ○食器洗い乾燥機専用洗剤代:475円(税込)/1箱(600g) ○手洗い用洗剤代:197円(税込)/315mL〔日本電機工業会調べ〕1日2回使用した場合の365日で算出。〔2024年7月現在〕
運転ラクラクの「オールトップコントロール」&「クイックスタート」機能
操作ボタンを上部に集中させた「オールトップコントロール」。かがまずラクな姿勢で操作できます。「クイックスタート」機能ならドアを開けてスタートボタンを押して、ドアを閉めるだけで、前回運転時のコースのまま、すぐに運転開始できます。

夜でも安心して洗える「サイレントコース」
運転音を気にされる方におすすめの「サイレントコース」。深型タイプなら36dB※1と夜をはじめ音が気になるシーンでも気をつかうことなく食器を洗えます。
※1 RSW-D401LPA・SD401LPA・D401GPA・SD401GPAシリーズ

美しくわかりやすい「ハーフミラー」&「運転行程お知らせランプ」
シンプルで美しいデザインの「ハーフミラー」。システムキッチンをよりスマートな外観に仕上げます。運転中は、「運転行程お知らせランプ」が運転の状況をわかりやすくお知らせするので、食器を追加したい時や終了時間の予測に便利です。
ハーフミラー

運転行程お知らせランプ

写真はRSW-D401LPAです。
商品仕様
| 品番 | RSW-SD401LPEA |
|---|---|
| メーカー | リンナイ |
| シリーズ | ディープ(深型)/ハイグレード/おかってカゴ |
| サイズ | 外形寸法:高さ753〜853×幅448×奥行き626mm |
| 重量 | 本体:21.5kg /脚ユニット:約2kg |
| 食器点数 | 37点(約4人分) |
| 庫内容積 | 約63L |
| 洗えるまな板の最大寸法 | 縦220×横400×厚さ15mm |
レビュー
住宅設備交換ならガス店【東京】へ
ガス店【東京】では、ガスコンロ・レンジフード・ビルトインオーブン・食洗機・給湯器など住宅設備機器の交換工事を承っております。商品選びからお見積り、施工まで自社スタッフが丁寧に対応し、安心してご利用いただけるサービスを提供しています。東京都・神奈川県・埼玉県・千葉県を中心に豊富な施工実績があり、各メーカーの商品にも幅広く対応可能です。工事費込みのわかりやすい価格設定で、交換をご検討中のお客様をサポートいたします。住宅設備の交換のことならお気軽にご相談ください。
【工事費込み】商品には、廃棄処分費や駐車場代などの諸経費も含まれています!事前のお知らせのない工事当日の追加請求はありません。現在の設置状況により追加部材やオプション費用が発生する場合がございますが、写真または無料現地調査で設置状況を確認しまして事前にお知らせいたしますのでご安心ください。
\ 廃棄処分費や駐車場代もコミコミで安心 /

全部コミコミ追加請求もないから安心です。
- 担当スタッフが丁寧かつスピーディーに対応いたします。
- 事前のお知らせのない当日の追加請求はありません。
- 経験豊富な資格保有スタッフが工事にお伺いします。
\ 熟練の有資格者がしっかりと対応 /

保有資格
- 簡易内管施工士
- ガス可とう管接続工事監督者
- ガス消費機器設置工事監督者
- 液化石油ガス設備士
- 給水装置工事主任技術者
- 第二種電気工事士
対応エリア
東京都
東京23区( 足立区、 荒川区、 板橋区、 江戸川区、 大田区、 葛飾区、 北区、 江東区、 品川区、 渋谷区、 新宿区、 杉並区、 墨田区、 世田谷区、 台東区、 中央区、 千代田区、 豊島区、 中野区、 練馬区、 文京区、 港区、 目黒区 )、 昭島市、 稲城市、 国立市、 狛江市、 国分寺市、 小金井市、 小平市、 清瀬市、 立川市、 多摩市、 調布市、 西東京市、 東久留米市、 東村山市、 東大和市、 日野市、 府中市、 三鷹市、 武蔵野市、 町田市神奈川県
川崎市( 麻生区、 川崎区、 幸区、 高津区、 多摩区、 中原区、 宮前区 )横浜市( 青葉区、 旭区、 泉区、 磯子区、 神奈川区、 金沢区、 港南区、 港北区、 栄区、 瀬谷区、 戸塚区、 都筑区、 鶴見区、 中区、 西区、 保土ヶ谷区、 緑区、 南区 )
鎌倉市、 逗子市、 藤沢市、 葉山町


![画像2: 【工事費込み】RSW-SD401LPEA[おかってカゴ][ハイグレード][自立脚付きタイプ]|リンナイ 食洗機 ドアパネル型|幅45cm・ディープタイプ・スライドオープン (2)](https://www.gas-ten.net/data/gas-ten/product/Rinnai/dishwasher/RSW-SD401LP_color.png)

![画像2: 【工事費込み】RSW-SD401LPEA[おかってカゴ][ハイグレード][自立脚付きタイプ]|リンナイ 食洗機 ドアパネル型|幅45cm・ディープタイプ・スライドオープン (2)](https://www.gas-ten.net/data/gas-ten/_/70726f647563742f52696e6e61692f646973687761736865722f5253572d53443430314c505f636f6c6f722e706e67003135300000740066.jpg)











